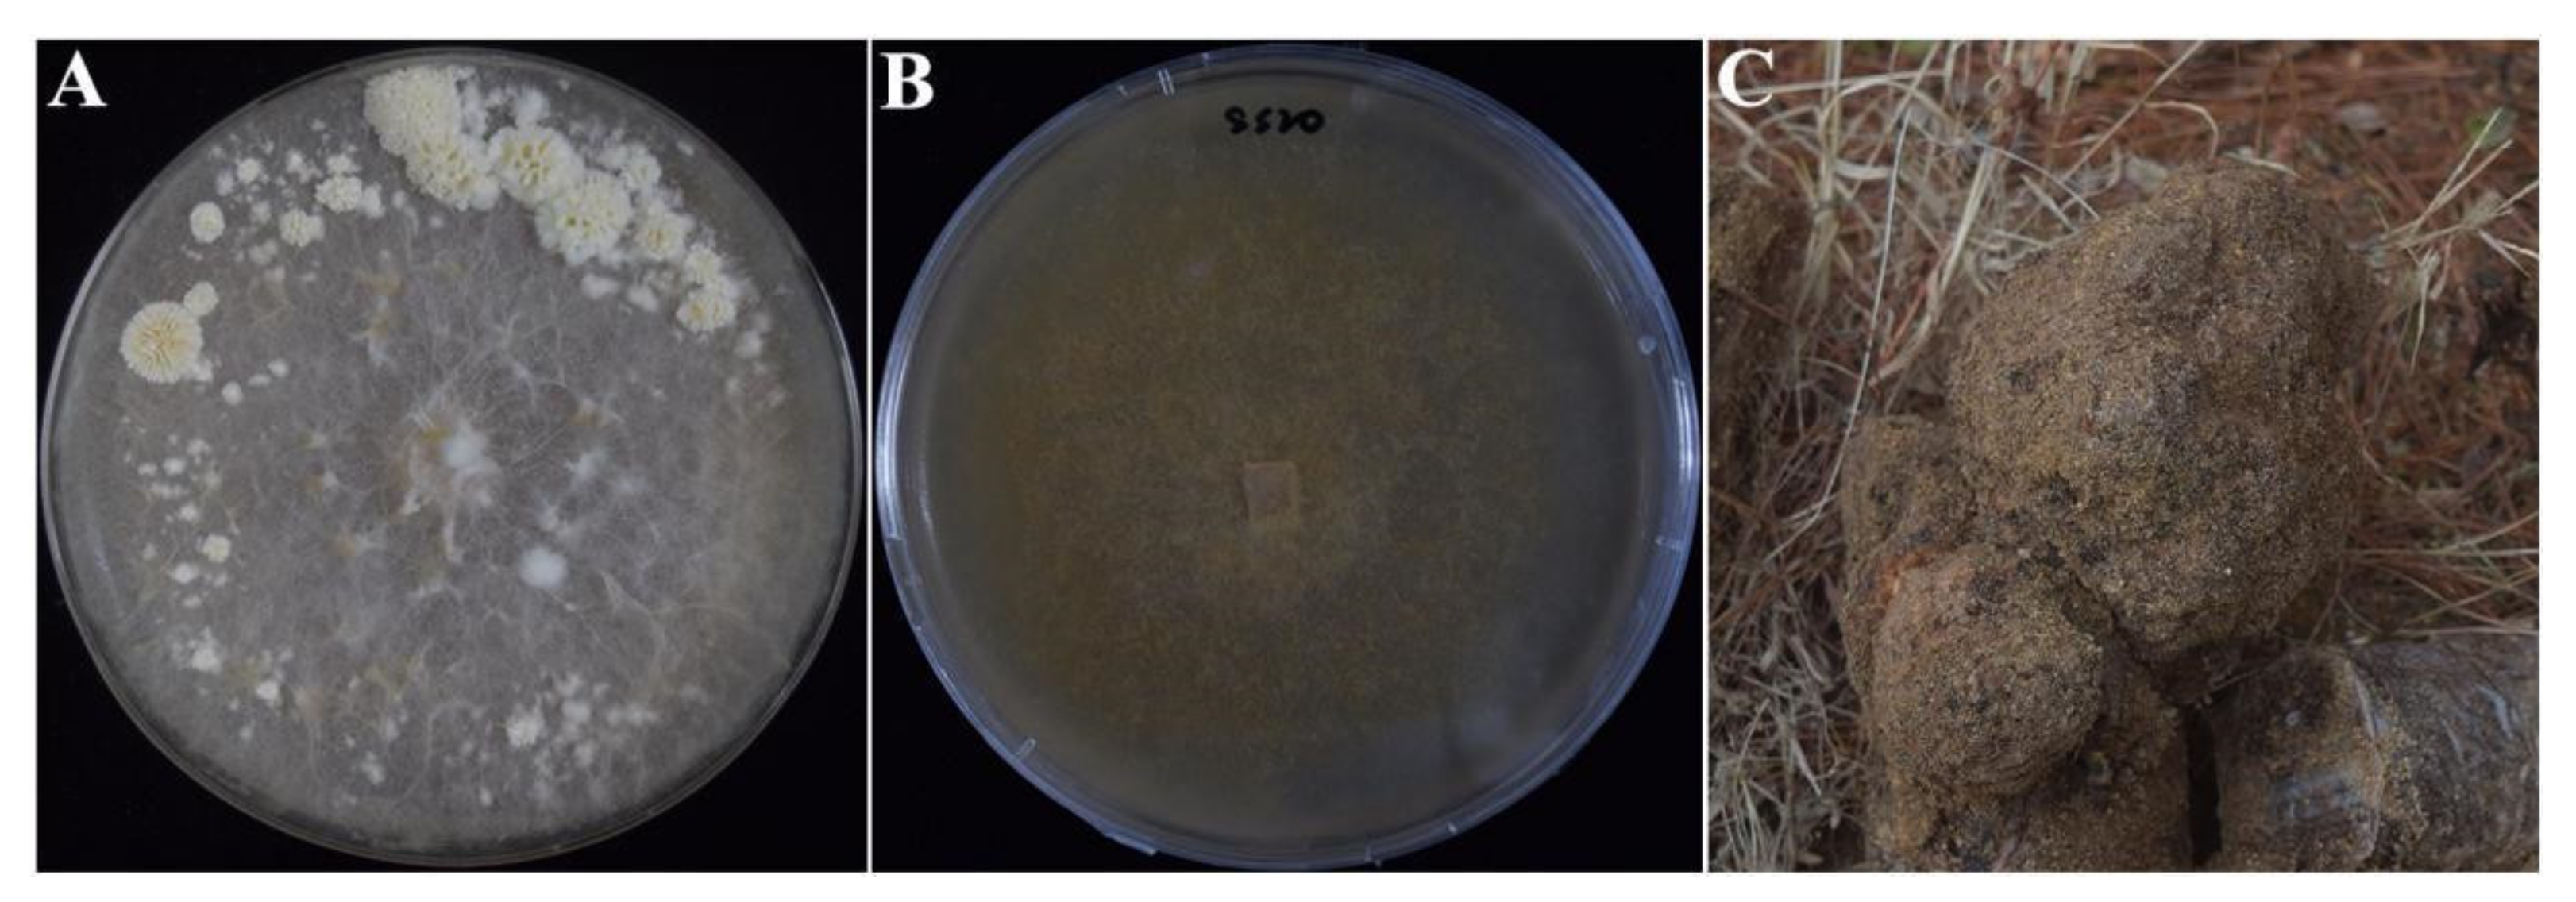
Ijms 23 10484 g010

Homokaryotic High-Quality Genome Assembly of Medicinal Fungi Wolfiporia hoelen Reveals Auto-Regulation and High-Temperature Adaption of Probable Two-Speed Genome
Abstract
:1. Introduction
2. Results
2.1. Genome Sequencing and Assembly
2.2. Gene Prediction and Functional Annotation
2.3. Whole-Genome Collinearity Analysis of Wolfiporia cocos, Wolfiporia hoelen, and Laetiporus sulphureus
2.4. Is Chr14 Accessory Chromosome?
2.5. Whole-Genome Methylation and Methylation Level of Transposons
2.6. Phylogenetic Analysis and Gene Family Expansion Associated with Sclerotia
2.7. Mating Locus of W. hoelen
2.8. CAZymes Family Comparison and Oxalic Acid Synthetic Pathway
2.9. High-Temperature Adaption of W. hoelen Based on Transcriptome Analysis
3. Discussion
3.1. Ploidy, Chromosome Number, Telomere, Heterozygosity, and Genome Assembly
3.2. Two-Speed Genome and Homeostasis
3.3. High-Temperature Adaption Strategy
3.4. Gene Family Expansion for Sclerotial Development
4. Materials and Methods
4.1. Homokaryotic Strain Screening and DNA Preparation
4.2. Genome Sequencing and Assembly
4.3. Hi-C Sequencing and Assembly
4.4. Repeat Annotation, Gene Prediction, Gene Function, and Noncoding RNA Annotation
4.5. Transcriptome Sequencing and Analysis
4.6. Methylation Sequencing
4.7. Prediction of Secreted Proteins
4.8. Phylogenomic Analyses
4.9. Whole-Genome Collinearity Analysis
4.10. CAZymes (Carbohydrate-Active Enzymes) Family Annotation
4.11. Conserved Protein Domain and Motif Prediction
Supplementary Materials
Author Contributions
Funding
Institutional Review Board Statement
Informed Consent Statement
Data Availability Statement
Acknowledgments
Conflicts of Interest
References
- Yuan, Y.; Wang, Y.J.; Sun, G.P.; Wang, Y.R.; Cao, L.J.; Shen, Y.M.; Yuan, B.; Han, D.; Huang, L.Q. Archaeological evidence suggests earlier use of Ganoderma in Neolithic China. Chin. Sci. Bull. 2018, 13, 1180–1188. [Google Scholar] [CrossRef]
- Gu, G.G. Shennong’s Classic of Materia Medical; Yang, P.J., Ed.; Academy Press: Beijing, China, 2017. [Google Scholar]
- Bao, H.Y.; Yang, S.; Li, Q.J.; Bau, T.; Li, Y. Supplementary textual research on “Sanghuang”. J. Fungal Res. 2017, 4, 264–270. [Google Scholar] [CrossRef]
- Wu, F.; Li, S.J.; Dong, C.H.; Dai, Y.C.; Papp, V. The genus Pachyma (syn. Wolfiporia) reinstated and species clarification of the cultivated medicinal mushroom “Fuling” in China. Front. Microbiol. 2020, 11, 590788. [Google Scholar] [CrossRef]
- Stalpers, J.A.; Redhead, S.A.; May, T.W.; Rossman, A.Y.; Crouch, J.A.; Cubeta, M.A.; Dai, Y.C.; Kirschner, R.; Langer, G.J.; Larsson, K.H.; et al. Competing sexual-asexual generic names in Agaricomycotina (Basidiomycota) with recommendations for use. IMA Fungus 2021, 12, 22. [Google Scholar] [CrossRef] [PubMed]
- Wolf, F.A. The fruiting stage of the tuckahoe Pachyma cocos. J. Elisha Mitchell Sci. Soc. 1922, 38, 127–137. [Google Scholar]
- Xu, Z.Y.; Meng, H.; Xiong, H.; Bian, Y.B. Biological characteristics of teleomorph and optimized in vitro fruiting conditions of the Hoelen medicinal mushroom, Wolfiporia extensa (higher basidiomycetes). Int. J. Med. Mushrooms 2014, 5, 421–429. [Google Scholar] [CrossRef]
- Jo, W.S.; Lee, S.H.; Koo, J.; Ryu, S.; Kang, M.G.; Lim, S.Y.; Park, S.C. Morphological characteristics of fruitbodies and basidiospores of Wolfiporia extensa. J. Mushrooms 2017, 15, 54–56. [Google Scholar] [CrossRef]
- Li, S.J.; Wang, Q.; Dong, C.H. Distinguishing homokaryons and heterokaryons in medicinal polypore mushroom Wolfiporia cocos (Agaricomycetes) based on cultural and genetic characteristics. Front. Microbiol. 2021, 11, 596715. [Google Scholar] [CrossRef]
- Wang, K.Q.; Fu, J.; Shu, W.; Fang, H.; Deng, F. Review of Chinese traditional medicinal fungus: Wolfiporia cocos. Res. Inf. Tradit. Chin. Med. 2002, 6, 16–17. [Google Scholar] [CrossRef]
- Jo, W.S.; Hong, I.P.; Yoo, Y.B.; Park, S.D. Improvement on Artificial Cultivation Technique of Poria cocos in Korea. In Proceedings of the International Mycological Congress 10th IMC10, Bangkok, Thailand, 3–8 August 2014. [Google Scholar]
- Li, S.J.; Wang, Q.; Liu, Q.Z.; Dong, C.H. Current status and prospects of biological study and sclerotium cultivation of Wolfiporia cocos. Mycosystema 2019, 38, 1–12. [Google Scholar] [CrossRef]
- Pu, Y.W.; Liu, Z.J.; Tian, H.; Bao, Y.X. The immunomodulatory effect of Poria cocos polysaccharides is mediated by the Ca2+/PKC/p38/NF-κB signaling pathway in macrophages. Int. Immunopharmacol. 2019, 72, 252–257. [Google Scholar] [CrossRef] [PubMed]
- Shi, C.Y.; Ma, Q.H.; Ren, M.Y.; Liang, D.D.; Yu, Q.T.; Luo, J.B. Antitumor pharmacological mechanism of the oral liquid of Poria cocos polysaccharide. J. Ethnopharmacol. 2017, 209, 24–31. [Google Scholar] [CrossRef] [PubMed]
- Wang, N.N.; Zhang, Y.; Wang, X.P.; Huang, X.W.; Fei, Y.; Yu, Y.; Shou, D. Antioxidant property of water-soluble polysaccharides from Poria cocos wolf using different extraction methods. Int. J. Biol. Macromol. 2016, 83, 103–110. [Google Scholar] [CrossRef] [PubMed]
- Chen, B.S.; Wang, S.X.; Liu, G.Q.; Bao, L.; Huang, Y.; Zhao, R.L.; Liu, H.W. Anti-inflammatory diterpenes and steroids from peels of the cultivated edible mushroom Wolfiporia cocos. Phytochem. Lett. 2020, 36, 11–16. [Google Scholar] [CrossRef]
- Shu, S.H.; Chen, B.; Zhou, M.C.; Zhao, X.M.; Xia, H.Y.; Wang, M. De novo sequencing and transcriptome analysis of Wolfiporia cocos to reveal genes related to biosynthesis of triterpenoids. PLoS ONE 2013, 8, e71350. [Google Scholar] [CrossRef]
- Wu, Y.Y.; Zhu, W.J.; Wei, W.; Zhao, X.L.; Wang, Q.; Zeng, W.Y.; Zheng, Y.L.; Chen, P.; Zhang, S.P. De novo assembly and transcriptome analysis of sclerotial development in Wolfiporia cocos. Gene 2016, 588, 149–155. [Google Scholar] [CrossRef]
- Yang, L.; Tang, J.; Chen, J.J.; Peng, A.Y.; Wang, Q.M.; Rao, L.Q.; Yang, H.; Zhang, X.W.; Yang, H.Z.; Zhang, C.; et al. Transcriptome analysis of three cultivars of Poria cocos reveals genes related to the biosynthesis of polysaccharides. J. Asian Nat. Prod. Res. 2019, 21, 462–475. [Google Scholar] [CrossRef]
- Zhang, S.P.; Hu, B.X.; Wei, W.; Xiong, Y.; Zhu, W.J.; Peng, F.; Yu, Y.; Zheng, Y.L.; Chen, P. De novo analysis of Wolfiporia cocos transcriptome to reveal the differentially expressed carbohydrate-active enzymes (CAZymes) genes during the early stage of sclerotial growth. Front. Microbiol. 2016, 7, 1–8. [Google Scholar] [CrossRef]
- Wei, W.; Shu, S.H.; Zhu, W.J.; Xiong, Y.; Peng, F. The kinome of edible and medicinal fungus Wolfiporia cocos. Front. Microbiol. 2016, 7, 1495. [Google Scholar] [CrossRef]
- Zhu, W.J.; Wei, W.; Zhang, S.P.; Zheng, Y.L.; Chen, P.; Xu, X.W. The phosphatome of medicinal and edible fungus Wolfiporia cocos. Curr. Microbiol. 2018, 75, 124–131. [Google Scholar] [CrossRef]
- Luo, H.M.; Qian, J.; Xu, Z.C.; Liu, W.J.; Xu, L.; Li, Y.; Xu, J.; Zhang, J.H.; Xu, X.L.; Liu, C.; et al. The Wolfiporia cocos genome and transcriptome shed light on the formation of its edible and medicinal sclerotium. Genom. Proteom. Bioinform. 2020, 18, 13. [Google Scholar] [CrossRef] [PubMed]
- Cao, S.; Yang, Y.; Bi, G.Q.; Nelson, D.; Hu, S.; Makunga, N.P.; Yu, B.; Liu, X.; Li, X.H.; Hu, X.B. Genomic and transcriptomic insight of giant sclerotium formation of wood-decay fungi. Front. Microbiol. 2021, 12, 746121. [Google Scholar] [CrossRef] [PubMed]
- Dong, S.M.; Raffaele, S.; Kamoun, S. The two-speed genomes of filamentous pathogens: Waltz with plants. Curr. Opin. Genet. Dev. 2015, 35, 57–65. [Google Scholar] [CrossRef] [PubMed]
- Li, S.J.; Wang, Q.; Dong, C.H. Bipolar system of sexual incompatibility and heterothallic life cycle in the basidiomycetes Pachyma hoelen Fr. (Fuling). Mycologia 2022, 114, 63–75. [Google Scholar] [CrossRef] [PubMed]
- Wang, K.Q.; Huang, H. Chinese Fuling, Resource and Standardized Planting Base Construction; Hubei Science and Technology Press: Hubei, China, 2018. [Google Scholar]
- Liu, X.M.; Wu, X.L.; Gao, W.; Qu, J.B.; Chen, Q.; Huang, C.Y.; Zhang, J.X. Protective roles of trehalose in Pleurotus pulmonarius during heat stress response. J. Integr. Agric. 2019, 18, 184–193. [Google Scholar] [CrossRef]
- Floudas, D.; Binder, M.; Riley, R.; Barry, K.; Blanchette, R.A.; Henrissat, B.; Martínez, A.T.; Otillar, R.; Spatafora, J.W.; Yadav, J.S.; et al. The paleozoic origin of enzymatic lignin decomposition reconstructed from 31 fungal genomes. Science 2012, 336, 1715–1719. [Google Scholar] [CrossRef]
- Nagy, L.G.; Riley, R.; Tritt, A.; Adam, C.; Daum, C.; Floudas, D.; Sun, H.; Yadav, J.S.; Pangilinan, J.; Larsson, K.H.; et al. Comparative genomics of early-diverging mushroom-forming fungi provides insights into the origins of lignocellulose decay capabilities. Mol. Biol. Evol. 2015, 33, 959–970. [Google Scholar] [CrossRef]
- Shi, Y.J. Analysis of Metabolome of Quinoa under Water Stress Based on GC-MS. Master’s Thesis, Chengdu University, Chengdu China, 2019; pp. 1–104. [Google Scholar]
- Raza, A. Integrated Analysis of Transcriptome and Metabolome Reveals Insights for Cold Response in Rapeseed (Brassica napus L.). Ph.D. Thesis, Chinese Academy of Agricultural Sciences, Beijing China, 2021; pp. 1–99. [Google Scholar]
- Wang, Y.H. Exploration and Functional Analysis of Disease Defense Related Genes of Gastrodia elata forma glauca in Changbai Mountain. Ph.D. Thesis, Jilin Agricultural University, Changchun China, 2021; pp. 1–152. [Google Scholar]
- Zhang, J.F. Comparative Transcriptome Analyses of Rice Gene Expression Changes Triggered by Rhizoctonia solani AG1 IA Infection and Research of Resistance-Related Genes of Rice. Ph.D. Thesis, Sichuan Agricultural University, Chengdu China, 2018; pp. 1–142. [Google Scholar]
- Wei, X.Y. Study on the physiological and transcriptomics analysis of Reaumuria soongorica seedings under drought stress. Master’s Thesis, Gansu Agricultural University, Lanzhou, China, 2021; pp. 1–82. [Google Scholar]
- Dong, W.K. Study on Resistance Mechanism of Poa pratensis to Powdery Mildew (Blumeria graminis DC.). Ph.D. Thesis, Gansu Agricultural University, Lanzhou, China, 2020; pp. 1–150. [Google Scholar]
- Justo, A.; Miettinen, O.; Floudas, D.; Ortiz-Santana, B.; Sjökvist, E.; Lindner, D.; Nakasone, K.; Niemelä, T.; Ryvarden, L.; Hibbett, D.S.; et al. A revised family-level classification of the Polyporales (Basidiomycota). Fungal Biol. 2017, 121, 798–824. [Google Scholar] [CrossRef]
- James, T.Y.; Sun, S.; Li, W.; Heitman, J.; Kuo, H.C.; Lee, Y.H.; Asiegbu, F.O.; Olson, A. Polyporales genomes reveal the genetic architecture underlying tetrapolar and bipolar mating systems. Mycologia 2013, 105, 1374–1390. [Google Scholar] [CrossRef]
- Hartmann, F.E.; Duhamel, M.; Carpentier, F.; Hood, M.E.; Foulongne-Oriol, M.; Silar, P.; Malagnac, F.; Grognet, P.; Giraud, T. Recombination suppression and evolutionary strata around mating-type loci in fungi: Documenting patterns and understanding evolutionary and mechanistic causes. New Phytol. 2021, 229, 2470–2491. [Google Scholar] [CrossRef]
- Ma, W.J.; Carpentier, F.; Giraud, T.; Hood, M.E. Differential gene expression between fungal mating types is associated with sequence degeneration. Genome Biol. Evol. 2020, 12, 243–258. [Google Scholar] [CrossRef] [PubMed] [Green Version]
- Dai, Y.C.; Qin, G.F.; Xu, M.Q. The forest pathogens of root and butt rot in Northeast China. For. Res. 2000, 13, 15–22. [Google Scholar] [CrossRef]
- Dai, Y.C. Polypore diversity in China with an annotated checklist of Chinese Polypores. Mycoscience 2012, 53, 49–80. [Google Scholar] [CrossRef]
- Behrendt, C.J.; Blanchette, R.A. Biological processing of pine logs for pulp and paper production with Phlebiopsis gigantea. Appl. Environ. Microbiol. 1997, 63, 1995–2000. [Google Scholar] [CrossRef] [PubMed]
- Kameshwar, A.K.S.; Qin, W.S. Comparative study of genome-wide plant biomass-degrading cazymes in white rot, brown rot and soft rot fungi. Mycology 2017, 9, 1–13. [Google Scholar] [CrossRef] [PubMed]
- Kameshwar, A.K.S.; Ramos, L.P.; Qin, W.S. Cazymes-based ranking of fungi (cbrf): An interactive web database for identifying fungi with extrinsic plant biomass degrading abilities. Bioresour. Bioprocess 2019, 6, 51. [Google Scholar] [CrossRef]
- Arantes, V.; Qian, Y.H.; Milagres, A.M.F.; Jellison, J.; Goodell, B. Effect of pH and oxalic acid on the reduction of Fe3+ by a biomimetic chelator and on Fe3+ desorption/adsorption onto wood: Implications for brown-rot decay. Int. Biodeterior. Biodegrad. 2009, 63, 478–483. [Google Scholar] [CrossRef]
- Green, F.; Clausen, C.A.; Kuster, T.A.; Highley, T.L. Induction of polygalacturonase and the formation of oxalic acid by pectin in brown-rot fungi. World J. Microbiol. Biotechnol. 1995, 11, 519–524. [Google Scholar] [CrossRef]
- Zhang, X.; Ren, A.; Li, M.J.; Cao, P.F.; Chen, T.X.; Zhang, G.; Shi, L.; Jiang, A.L.; Zhao, M.W. Heat stress modulates mycelium growth, heat shock protein expression, ganoderic acid biosynthesis, and hyphal branching of Ganoderma lucidum via cytosolic Ca2+. Appl. Environ. Microbiol. 2016, 82, 4112–4125. [Google Scholar] [CrossRef]
- Tominaga, Y. Study on life-cycle of Wolfiporia cocos. Foreign Edible Mushroom. Foreign Agron. 1991, 1, 29–32. [Google Scholar] [CrossRef]
- Wang, Q.H.; Jiang, C.; Wang, C.F.; Chen, C.J.; Xu, J.R.; Liu, H.Q. Characterization of the two-speed subgenomes of Fusarium graminearum reveals the fast-speed subgenome specialized for adaption and infection. Front. Plant Sci. 2017, 8, 140. [Google Scholar] [CrossRef] [PubMed] [Green Version]
- Thomma, B.P.H.J.; Faino, L.; Li, J.; Shi-Kunne, X.; Depotter, J.R.L.; Kramer, H.M.; van den Berg-Velthuis, G.C.M.; Cook III, D.; Rövenich, H.J.; Seidl, M.F. The Two-Speed Genome of Verticillium dahliae Mediates Emergence of Potent Virulence Factors. In Proceedings of the 29th Fungal Genetics Conference, Pacific Grove, CA, USA, 14–19 March 2017. [Google Scholar]
- Haas, B.J.; Kamoun, S.; Zody, M.C.; Jiang, R.H.Y.; Handsaker, R.E.; Cano, L.M.; Grabherr, M.; Kodira, C.D.; Raffaele, S.; Torto-Alalibo, T. Genome sequence and analysis of the Irish potato famine pathogen Phytophthora infestans. Nature 2009, 461, 393–398. [Google Scholar] [CrossRef] [PubMed]
- Wu, G.; Miyauchi, S.; Morin, E.; Kuo, A.; Drula, E.; Varga, T.; Kohler, A.; Feng, B.; Cao, Y.; Lipzen, A.; et al. Evolutionary innovations through gain and loss of genes in the ectomycorrhizal Boletales. New Phytol. 2022, 233, 1383–1400. [Google Scholar] [CrossRef]
- Zhang, X.Y.; Yazaki, J.; Sundaresan, A.; Cokus, S.; Chan, S.W.L.; Chen, H.M.; Henderson, I.R.; Shinn, P.; Pellegrini, M.; Jacobsen, S.E.; et al. Genome-wide high-resolution mapping and functional analysis of DNA methylation in Arabidopsis. Cell 2006, 126, 1–13. [Google Scholar] [CrossRef]
- Zilberman, D.; Gehring, M.; Tran, R.K.; Ballinger, T.; Henikoff, S. Genome-wide analysis of Arabidopsis thaliana DNA methylation uncovers an interdependence between methylation and transcription. Nat. Genet. 2007, 39, 61–69. [Google Scholar] [CrossRef]
- Qiu, L.Y.; Yv, C.; Qi, Y.C.; Gao, Y.Q.; Shen, J.W. Research progress of fungal epigenetics. Chin. J. Cell Biol. 2009, 31, 212–216. [Google Scholar]
- Evans, H.H.; Evans, T.E. Methylation of the deoxyribonucleic acid of Physarum polycephalum at various periods during the mitotic cycle. J. Bio. Chem. 1970, 245, 6436–6441. [Google Scholar] [CrossRef]
- Zemach, A.; Mcdaniel, I.E.; Silva, P.; Zilberman, D. Genome-wide evolutionary analysis of eukaryotic DNA methylation. Science 2010, 328, 916–919. [Google Scholar] [CrossRef]
- Capuano, F.; Mülleder, M.; Kok, R.; Blom, H.J.; Ralser, M. Cytosine DNA methylation is found in Drosophila melanogaster but absent in Saccharomyces cerevisiae, Schizosaccharomyces pombe, and other yeast species. Anal. Chem. 2014, 86, 3697–3702. [Google Scholar] [CrossRef]
- Wang, H.M.; Fan, L.G.; Dong, Y.R.; Zheng, X.H.; Liu, H.Q. High-quality genome assembly and DNA N6-methyladenine analysis of Morchella sextelata strain SCLS using PacBio SMRT sequencing. Mycosystema 2021, 40, 2299–2316. [Google Scholar] [CrossRef]
- Zhang, T.J.; Shi, L.; Chen, D.D.; Liu, R.; Shi, D.K.; Wu, C.G.; Sun, Z.H.; Ren, A.; Zhao, M.W. 14-3-3 proteins are involved in growth, hyphal branching, ganoderic acid biosynthesis, and response to abiotic stress in Ganoderma lucidum. Appl. Microbiol. Biotechnol. 2018, 102, 1769–1782. [Google Scholar] [CrossRef] [PubMed]
- Pucciariello, C.; Banti, V.; Perata, P. ROS signaling as common element in low oxygen and heat stresses. Plant Physiol. Biochem. 2012, 59, 3–10. [Google Scholar] [CrossRef] [PubMed] [Green Version]
- Holthuis, J.C.M.; Menon, A.K. Lipid landscapes and pipelines in membrane homeostasis. Nature 2014, 510, 48–57. [Google Scholar] [CrossRef] [PubMed]
- Aguilar-Uscanga, B.; Francois, J.M. A study of the yeast cell wall composition and structure in response to growth conditions and mode of cultivation. Lett. Appl. Microbiol. 2010, 37, 268–274. [Google Scholar] [CrossRef]
- Hu, Y.R.; Xu, W.Z.; Hu, S.S.; Lian, L.D.; Zhu, J.; Ren, A.; Shi, L.; Zhao, M.W. Glsnf1-mediated metabolic rearrangement participates in coping with heat stress and influencing secondary metabolism in Ganoderma lucidum. Free. Radic. Biol. Med. 2020, 147, 220–230. [Google Scholar] [CrossRef]
- Tang, L.H.; Yang, R.H.; Shang, J.J.; Song, C.Y.; Bao, D.P.; Tan, Q. Autophagy and apoptosis are associated with light-induced mycelia brown film formation in Lentinula edodes. In Proceedings of the Conference proceedings of the Academic Annual Meeting of the Chinese Society of Mycology, Shanghai, China, 12–15 November 2018. [Google Scholar]
- Sun, X.Y.; Liu, D.M.; Wang, Y.Y.; Ma, A.M. Biogenesis of macrofungal sclerotia: Influencing factors and molecular mechanisms. Appl. Microbiol. Biotechnol. 2020, 104, 4227–4234. [Google Scholar] [CrossRef]
- Meyne, J.; Ratliff, R.L.; Moyzis, R.K. Conservation of the human telomere sequence (TTAGGG)n among vertebrates. Proc. Natl. Acad. Sci. USA 1989, 86, 7046–7053. [Google Scholar] [CrossRef]
- Servant, N.; Varoquaux, N.; Lajoie, B.R.; Viara, E.; Chen, C.J.; Vert, J.P.; Heard, E.; Dekker, J.; Barillot, E. HiC-Pro: An optimized and flexible pipeline for Hi-C data processing. Genome Biol. 2015, 16, 259. [Google Scholar] [CrossRef]
- Burton, J.N.; Adey, A.; Patwardhan, R.P.; Qiu, R.L.; Kitzman, J.O.; Shendure, J. Chromosome-scale scaffolding of de novo genome assemblies based on chromatin interactions. Nat. Biotechnol. 2013, 31, 1119–1125. [Google Scholar] [CrossRef]
- Wang, X.W.; Wang, L. GMATA: An integrated software package for genome-scale SSR mining, marker development and viewing. Front. Plant Sci. 2016, 7, 1350. [Google Scholar] [CrossRef]
- Bao, W.D.; Kojima, K.K.; Kohany, O. Repbase Update, a database of repetitive elements in eukaryotic genomes. Mob DNA 2015, 6, 11. [Google Scholar] [CrossRef]
- Keilwagen, J.; Hartung, F.; Grau, J. GeMoMa: Homology-based gene prediction utilizing intron position conservation and RNA-seq data. Methods Mol Biol 2019, 1962, 161–177 DOI 101007/978. [Google Scholar] [PubMed]
- TransposonPSI: An application of PSI-blast to mine (retro-)transposon ORF homologies. Available online: http://transposonpsi.%20sourceforge.net/ (accessed on 15 November 2020).
- Lowe, T.M.; Eddy, S.R. tRNAscan-SE: A program for improved detection of transfer RNA genes in genomic sequence. Nucleic Acids Res. 1997, 25, 955–964. [Google Scholar] [CrossRef] [PubMed]
- Griffiths-Jones, S.; Bateman, A.; Marshall, M.; Khanna,, A.; Eddy, S.R. Rfam: An RNA family database. Nucleic Acids Res. 2003, 31, 439–441. [Google Scholar] [CrossRef]
- Lagesen, K.; Hallin, P.; Rødland, E.A.; Stærfeldt, H.H.; Rognes, T.; Ussery, D.W. RNAmmer: Consistent and rapid annotation of ribosomal RNA genes. Nucleic Acids Res. 2007, 35, 3100–3108. [Google Scholar] [CrossRef]
- Bolger, A.M.; Lohse, M.; Usadel, B. Trimmomatic: A flexible trimmer for Illumina sequence data. Bioinformatics 2014, 30, 2114–2120. [Google Scholar] [CrossRef]
- Xi, Y.X.; Li, W. BSMAP: Whole genome bisulfite sequence mapping program. BMC Bioinform. 2009, 10, 1–9. [Google Scholar] [CrossRef]
- Lister, R.; O’Malley, R.C.; Tonti-Filippini, J.; Gregory, B.D.; Berry, C.C.; Millar, A.H.; Ecker, J.R. Highly integrated single-base resolution maps of the epigenome in Arabidopsis. Cell 2008, 133, 523–536. [Google Scholar] [CrossRef]
- Petersen, T.N.; Brunak, S.; Heijne, G.V.; Nielsen, H. SIGNALP 4.0: Discriminating signal peptides from transmembrane regions. Nat. Methods 2011, 8, 785–786. [Google Scholar] [CrossRef]
- Emanuelsson, O.; Nielsen, O.; Brunak, S.; von Heijne, G. Predicting subcellular localization of proteins based on their N-terminal amino acid sequence. J. Mol. Biol. 2000, 300, 1005–1016. [Google Scholar] [CrossRef]
- Krogh, A.; Larsson, B.; von Heijne, G.; Sonnhammer, E.L. Predicting transmembrane protein topology with a hidden Markov model: Application to complete genomes. J. Mol. Biol. 2001, 305, 567–580. [Google Scholar] [CrossRef] [PubMed]
- Horton, P.; Park, K.J.; Obayashi, T.; Fujita, N.; Harada, H.; Adams-Collier, C.J.; Nakai, K. WoLF PSORT: Rotein localization predictor. Nucleic Acids Res. 2007, 35, W585–W587. [Google Scholar] [CrossRef] [PubMed] [Green Version]
- Emms, D.M.; Kelly, S. OrthoFinder: Solving fundamental biases in whole genome comparisons dramatically improves orthogroup inference accuracy. Genome. Biol. 2015, 16, 157. [Google Scholar] [CrossRef] [PubMed]
- Madeira, F.; Pearce, M.; Tivey, A.R.N.; Basutkar, P.; Lee, J.; Edbali, O.; Madhusoodanan, N.; Kolesnikov, A.; Lopez, R. Search and sequence analysis tools services from EMBL-EBI in 2022. Nucleic Acids Res. 2022, 50, W276–W279. [Google Scholar] [CrossRef]
- Castresana, J. Selection of conserved blocks from multiple alignments for their use in phylogenetic analysis. Mol. Biol. Evol. 2000, 17, 540–552. [Google Scholar] [CrossRef]
- Zhang, D.; Gao, F.L.; Li, W.X.; Jakovlić, I.; Zou, H.; Zhang, J.; Wang, G.T. PhyloSuite: An integrated and scalable desktop platform for streamlined molecular sequence data management and evolutionary phylogenetics studies. Mol. Ecol. Resour. 2020, 20, 348–355. [Google Scholar] [CrossRef]
- Kozlov, A.M.; Darriba, D.; Flouri, T.; Morel, B.; Stamatakis, A. Raxml-ng: A fast, scalable, and user-friendly tool for maximum likelihood phylogenetic inference. Bioinformatics 2019, 21, 1–3. [Google Scholar] [CrossRef]
- Rambaut, A. FigTree: Tree Figure Drawing Tool, Version 1.3.1., Institute of Evolutionary Biology, University of Edinburgh: Edinburgh, Scotland. 2009. Available online: http://tree.bio.ed.ac.uk/ (accessed on 10 November 2018).
- Chen, C.J.; Chen, H.; Zhang, Y.; Thomas, H.R.; Frank, M.H.; He, Y.H.; Xia, R. Tbtools: An integrative toolkit developed for interactive analyses of big biological data. Mol. Plant 2020, 13, 9. [Google Scholar] [CrossRef]
- Zhang, H.; Yohe, T.; Huang, L.; Entwistle, S.; Wu, P.Z.; Yang, Z.L.; Busk, P.K.; Xu, Y.; Yin, Y.B. dbCAN2: A meta server for automated carbohydrate-active enzyme annotation. Nucleic Acids Res. 2018, 46, W95–W101. [Google Scholar] [CrossRef]
- Schwede, T.; Kopp, J.; Guex, N.; Peitsch, M.C. SWISS-MODEL: An automated protein homology-modeling server. Nucleic Acids Res. 2003, 31, 3381–3385. [Google Scholar] [CrossRef]
- Crooks, G.E.; Hon, G.; Chandonia, J.M.; Brenner, S.E. WebLogo: A sequence logo generator. Genome Res. 2004, 14, 1188–1190. [Google Scholar] [CrossRef] [PubMed] [Green Version]

| Class | Order | Super Family | Number of Elements | Length of Sequence (bp) | Percentage of Sequence (%) |
|---|---|---|---|---|---|
| Class I | 39,473 | 23,696,976 | 36.76 | ||
| LTR | 35,804 | 22,399,747 | 34.74 | ||
| Gypsy | 18,134 | 16,432,277 | 25.49 | ||
| Unknown | 16,685 | 5,739,423 | 8.9 | ||
| Copia | 896 | 168,232 | 0.26 | ||
| Other | 89 | 59,815 | 0.09 | ||
| LINE | 3189 | 1,222,889 | 1.9 | ||
| Unknown | 2902 | 1,053,895 | 1.63 | ||
| Tad1 | 258 | 163,271 | 0.25 | ||
| Other | 29 | 5723 | 0.01 | ||
| SINE | 480 | 74,340 | 0.12 | ||
| Unknown | 480 | 74,340 | 0.12 | ||
| Class II | 14,698 | 6,127,627 | 9.5 | ||
| DNA | 6000 | 3,580,746 | 5.55 | ||
| MULE-MuDR | 175 | 156,180 | 0.24 | ||
| Unknown | 5286 | 3,106,855 | 4.82 | ||
| TcMar-Sagan | 274 | 121,948 | 0.19 | ||
| Other | 265 | 195,763 | 0.3 | ||
| MITE | 8620 | 2,398,308 | 3.72 | ||
| Unknown | 8620 | 2,398,308 | 3.72 | ||
| RC | 78 | 148,573 | 0.23 | ||
| Helitron | 78 | 148,573 | 0.23 | ||
| Total TEs | 54,171 | 29,824,603 | 46.26 | ||
| Tandem Repeats | 3964 | 152,603 | 0.24 | ||
| tandem_repeat | 2380 | 133,712 | 0.21 | ||
| SSR | 1584 | 18,891 | 0.03 | ||
| Unknown | 4778 | 1,324,782 | 2.05 | ||
| Simple repeats | 82 | 7498 | 0.01 | ||
| Other | 5 | 274 | 0 | ||
| Low complexity | 1 | 221 | 0 | ||
| Total Repeats | 63,001 | 31,309,981 | 48.56 |
| CGMCC 5.78 | WCLT | SS20 | |
|---|---|---|---|
| Sequencing strategy | HiSeq 2000 Illumina and a fosmid-to fosmid strategy | HiSeq2500 Illumina and SMRT technology on the PacBio | Novaseq6000 Illumina and SMRT technology on the PacBio |
| Genome size (Mb) | 50.6 | 62 | 64.44 |
| Number of scaffolds | 351 | 145 | 78 |
| N50 of scaffolds (kb) | 835 | 1599.1 | 3760 |
| Anchored to chromosome (Mb) | 61.127 | 58.26 | |
| Number of protein-coding genes | 10,908 | 11,906 | 10,567 |
| Average gene length (bp) | 1829 | 1332.76 | 2004 |
| Percentage of repeat sequences (%) | - | 46.6 | 48.56 |
| Transposable elements (%) | 33.5 | - | 46.26 |
| GC content (%) | 51.7 | 51.86 | 50.15 |
| Reference | [23] | [24] | This study |
| Wolfiporia hoelen | Chr01 | Chr02 | Chr03 | Chr04 | Chr05 | Chr06 | Chr07 |
|---|---|---|---|---|---|---|---|
| Wolfiporia cocos | 76.88% | 82.98% | 73.80% | 76.48% | 79.31% | 81.90% | 73.20% |
| Laetiporus sulphureus | 63.38% | 70.10% | 56.19% | 51.03% | 57.79% | 71.64% | 56.80% |
| Wolfiporia hoelen | Chr08 | Chr09 | Chr10 | Chr11 | Chr12 | Chr13 | Chr14 |
| Wolfipoira cocos | 67.26% | 68.89% | 69.84% | 77.04% | 72.06% | 75.51% | 29.34% |
| Laetiporus sulphureus | 39.64% | 46.95% | 48.79% | 38.90% | 35.03% | 39.33% | 0% |
Publisher’s Note: MDPI stays neutral with regard to jurisdictional claims in published maps and institutional affiliations. |
© 2022 by the authors. Licensee MDPI, Basel, Switzerland. This article is an open access article distributed under the terms and conditions of the Creative Commons Attribution (CC BY) license (https://creativecommons.org/licenses/by/4.0/).
Share and Cite
Li, S.; Meng, G.; Dong, C. Homokaryotic High-Quality Genome Assembly of Medicinal Fungi Wolfiporia hoelen Reveals Auto-Regulation and High-Temperature Adaption of Probable Two-Speed Genome. Int. J. Mol. Sci. 2022, 23, 10484. https://doi.org/10.3390/ijms231810484
Li S, Meng G, Dong C. Homokaryotic High-Quality Genome Assembly of Medicinal Fungi Wolfiporia hoelen Reveals Auto-Regulation and High-Temperature Adaption of Probable Two-Speed Genome. International Journal of Molecular Sciences. 2022; 23(18):10484. https://doi.org/10.3390/ijms231810484
Chicago/Turabian StyleLi, Shoujian, Guoliang Meng, and Caihong Dong. 2022. "Homokaryotic High-Quality Genome Assembly of Medicinal Fungi Wolfiporia hoelen Reveals Auto-Regulation and High-Temperature Adaption of Probable Two-Speed Genome" International Journal of Molecular Sciences 23, no. 18: 10484. https://doi.org/10.3390/ijms231810484
APA StyleLi, S., Meng, G., & Dong, C. (2022). Homokaryotic High-Quality Genome Assembly of Medicinal Fungi Wolfiporia hoelen Reveals Auto-Regulation and High-Temperature Adaption of Probable Two-Speed Genome. International Journal of Molecular Sciences, 23(18), 10484. https://doi.org/10.3390/ijms231810484








